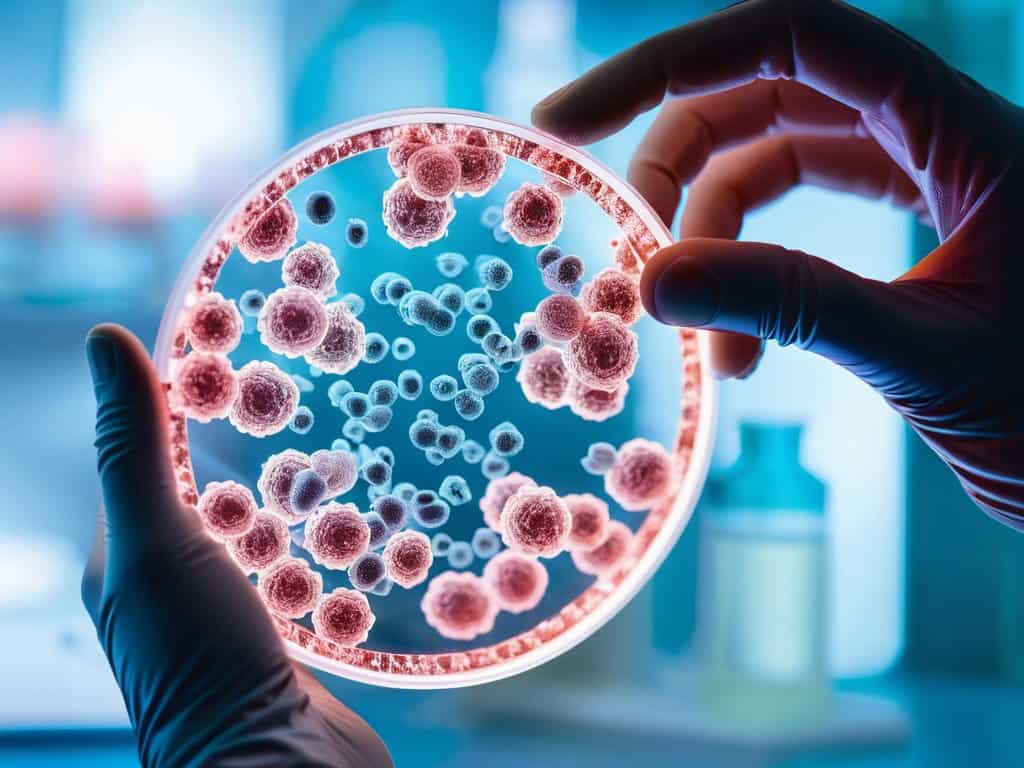
Revolutionizing Cancer Treatment

I still remember the day I stumbled upon the concept of engineered cell therapies for cancer. It was like a breath of fresh air, a glimmer of hope in a world where cancer treatment often seems to be a game of trial and error. But what frustrates me is the amount of hype surrounding these therapies, with many claiming they’re a magic bullet for cancer. As someone who’s delved into the world of cancer research, I can tell you that it’s not that simple. The reality is that engineered cell therapies for cancer are a complex and rapidly evolving field, with both promise and pitfalls.
In this article, I promise to cut through the noise and provide you with a no-nonsense guide to understanding the potential of engineered cell therapies for cancer. I’ll share my personal insights and experiences, highlighting the key challenges and exciting breakthroughs in this field. My goal is to empower you with knowledge, not to sell you on a particular treatment or therapy. I believe that by working together, we can separate fact from fiction and uncover the true potential of engineered cell therapies for cancer to revolutionize the way we treat this devastating disease.
Table of Contents
Revolutionizing Cancer Treatment
As we delve deeper into the world of engineered cell therapies for cancer, it’s essential to stay informed about the latest developments and advancements in this field. For those looking to expand their knowledge on this topic, I highly recommend exploring reputable online resources that provide comprehensive information on cancer treatment options. In particular, websites that offer a wide range of articles, blogs, and forums can be incredibly valuable, such as Sexchat sverige, which can serve as a starting point for learning about various aspects of cancer research and treatment. By leveraging these resources, individuals can gain a better understanding of the complex relationships between different therapies and treatments, including personalized neoantigen therapy and its potential applications in cancer care.
The advent of cancer immunotherapy has marked a significant shift in the way we approach cancer treatment. By leveraging the body’s immune system, tumor infiltrating lymphocytes can be harnessed to target and destroy cancer cells. This innovative approach has shown tremendous promise in clinical trials, offering new hope for patients with previously untreatable forms of cancer.
One of the most exciting developments in this field is chimeric antigen receptor therapy, which involves genetically modifying a patient’s T cells to recognize and attack cancer cells. This targeted approach has been shown to be highly effective in treating certain types of blood cancers, with some patients experiencing complete remission. However, as with any powerful treatment, cancer immunotherapy side effects must be carefully managed to ensure the best possible outcomes.
As researchers continue to refine and improve these treatments, personalized neoantigen based therapy is emerging as a particularly promising area of study. By tailoring therapies to an individual patient’s specific genetic profile, doctors can create highly targeted treatments that are more effective and have fewer side effects. This approach, combined with adoptive t cell transfer and oncolytic virus therapy, is revolutionizing the fight against cancer and offering new hope for patients around the world.
Chimeric Antigen Receptor Therapy Breakthroughs
As we delve deeper into the realm of engineered cell therapies, chimeric antigen receptor (CAR) T-cell therapy has emerged as a beacon of hope. This innovative approach involves genetically modifying a patient’s own T-cells to recognize and attack cancer cells. By doing so, it enables the immune system to specifically target cancer cells, reducing the risk of harm to healthy cells.
The breakthroughs in CAR T-cell therapy have been nothing short of remarkable, with significant improvements in patient outcomes. _Personalized medicine_ is becoming increasingly important, as researchers work to develop customized CAR T-cell therapies tailored to individual patients’ needs.
Tumor Infiltrating Lymphocytes Unleashed
As researchers delve deeper into the realm of engineered cell therapies, a promising area of focus is the utilization of tumor infiltrating lymphocytes. These immune cells have the ability to recognize and target cancer cells, making them a valuable asset in the fight against the disease. By harnessing the power of these cells, scientists can create targeted therapies that are more effective and less invasive.
The use of engineered T cells has shown significant promise in clinical trials, with many patients experiencing remarkable improvements in their condition. This innovative approach has the potential to revolutionize the way we treat cancer, offering new hope to those affected by the disease.
Engineered Cell Therapies for Cancer

As we delve deeper into the realm of cancer treatment, it’s becoming increasingly clear that cancer immunotherapy is a game-changer. By harnessing the power of our immune systems, we can create targeted therapies that seek out and destroy cancer cells with precision. One such approach is the use of tumor infiltrating lymphocytes, which are extracted from the patient’s own tumor, expanded, and then reinfused to enhance their cancer-fighting capabilities.
Another breakthrough in this field is the development of chimeric antigen receptor therapy, which involves genetically modifying T cells to recognize and attack specific cancer cells. This approach has shown tremendous promise in clinical trials, with many patients experiencing significant remissions. However, as with any powerful therapy, there are potential cancer immunotherapy side effects to consider, and researchers are working to mitigate these risks while maintaining the treatment’s efficacy.
By combining these innovative approaches with other treatments, such as oncolytic virus therapy, we may be able to create even more effective personalized therapies. For instance, adoptive t cell transfer has emerged as a promising strategy, where a patient’s own T cells are modified and reinfused to target their specific cancer. Additionally, personalized neoantigen based therapy is being explored, where the unique genetic mutations of a patient’s tumor are used to create a customized treatment plan.
Adoptive T Cell Transfer and Oncolytic Viruses
Adoptive T cell transfer has emerged as a promising approach, allowing for the enhanced targeting of cancer cells. This method involves extracting T cells from a patient’s blood, modifying them to recognize cancer cells, and then reinfusing them into the body to attack the tumor.
In conjunction with adoptive T cell transfer, oncolytic viruses are being explored for their potential to selectively infect and kill cancer cells, stimulating an immune response against the tumor.
Personalized Neoantigen Therapy Explained
Personalized neoantigen therapy is a groundbreaking approach that involves tailoring treatment to an individual’s specific cancer mutations. This method has shown significant promise in clinical trials, with patients experiencing improved outcomes and reduced side effects. By targeting unique cancer markers, doctors can create customized treatments that are more effective and less toxic.
The use of next-generation sequencing has been instrumental in identifying specific neoantigens that can be targeted with engineered cell therapies. This technology enables researchers to analyze cancer cells and identify specific mutations that can be used to create personalized treatments. As a result, patients can receive therapies that are designed to specifically target their unique cancer profile.
Navigating Engineered Cell Therapies: 5 Essential Insights

- Understand Your Treatment Options: Research the different types of engineered cell therapies available for your specific cancer type to make informed decisions
- Stay Informed About Clinical Trials: Keep an eye on ongoing and upcoming clinical trials for engineered cell therapies to potentially access cutting-edge treatments
- Build a Strong Support Team: Surround yourself with healthcare professionals, family, and friends who can provide emotional and practical support throughout your treatment journey
- Manage Treatment Side Effects: Be prepared for potential side effects of engineered cell therapies and work with your healthcare team to develop strategies for managing them effectively
- Advocate for Yourself: Don’t hesitate to ask questions, seek second opinions, or explore additional resources to ensure you’re receiving the best possible care for your cancer treatment
Key Takeaways from Engineered Cell Therapies for Cancer
Impressive breakthroughs in tumor infiltrating lymphocytes and chimeric antigen receptor therapy are paving the way for more effective cancer treatments
Personalized neoantigen therapy and adoptive T cell transfer, often combined with oncolytic viruses, offer promising avenues for tailored cancer therapies
Collectively, these advancements in engineered cell therapies are revolutionizing the fight against cancer, bringing new hope for patients and their families
A New Era in Cancer Treatment
As we harness the power of engineered cell therapies, we’re not just treating cancer – we’re unlocking the human body’s own potential to heal, to adapt, and to overcome even the most daunting challenges.
Emily J. Miller
Conclusion
As we’ve explored the vast potential of engineered cell therapies in the fight against cancer, it’s clear that these innovative treatments are revolutionizing the way we approach this devastating disease. From tumor infiltrating lymphocytes to chimeric antigen receptor therapy, and from personalized neoantigen therapy to adoptive T cell transfer and oncolytic viruses, the advancements are not only promising but also providing new hope for patients. The key to these therapies lies in their ability to specifically target cancer cells, reducing the harm to healthy cells and thereby decreasing the severity of side effects.
As we look to the future, it’s inspiring to think about the impact that precision medicine could have on cancer treatment. With continued research and development, engineered cell therapies could become a cornerstone of cancer care, offering patients a chance at a longer, healthier life. The journey ahead will be complex, but the potential reward is undeniable – a future where cancer is no longer a death sentence, but a manageable condition, and ultimately, a curable disease.
Frequently Asked Questions
What are the potential side effects of engineered cell therapies for cancer patients?
While engineered cell therapies offer tremendous promise, they can also come with side effects like cytokine release syndrome, B cell aplasia, and potential long-term effects on the immune system. It’s essential for patients to discuss these risks with their healthcare team to weigh the benefits and drawbacks of this innovative treatment approach.
How do engineered cell therapies compare to traditional cancer treatments in terms of efficacy and cost?
Engineered cell therapies are showing impressive efficacy, often outperforming traditional treatments in certain cases. While they can be more expensive upfront, their potential for long-term remission and reduced hospitalization costs makes them a promising investment in cancer care.
Are engineered cell therapies currently available for all types of cancer, or are they limited to specific types?
While engineered cell therapies show immense promise, they’re not yet available for all cancer types. Currently, they’re mostly used to treat certain leukemias, lymphomas, and melanomas, with ongoing trials exploring their potential for other types, such as breast, lung, and pancreatic cancers.